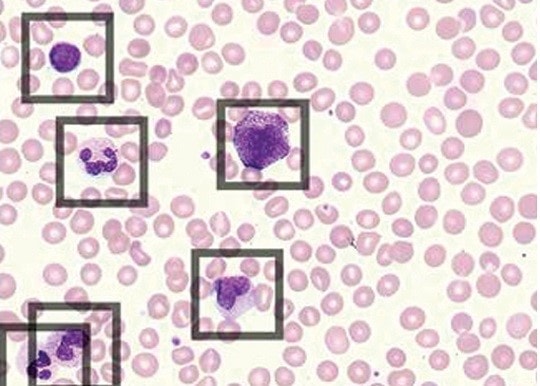

DxH 900 Workcell Automated Hematology Solution
Streamline processes with our automated hematology system. Fully scalable and customizable, the workcell features an integrated line with a seamless connection to attached units for intelligently distribute workloads.
Redefining High-Throughput Hematology Workflow
The DxH 900 Workcell Solution provides unparalleled first-run accuracy giving you increased confidence in your results. Expand your hematology capabilities, extend walk away time and optimize your inventory management with DxH Concentrated ECO Diluent.
Webinar Full-Field & Fully Digital: The Future of Digital Hematology
Watch this on-demand webinar to hear Robin Johnson lab director at Vista Clinical Diagnostics and and Ahmed Bentahar medical director at Beckman Coulter as they discuss how digital hematology solutions are improving lab performance.
Register hereCasebook Digital Hematology: Advanced Technology Guide
With its advanced theory of operation and near-native cellular characterization, DxH 900 & 690T hematology analyzer technology allows for effective cellular analysis to accurately analyze blood cells and provide clinically significant data to aid in disease identification. Download the casebook to learn more.
Download casebook
Blog
Concentrating on Our Planet
We are dedicated to protecting our natural resources through new laboratory innovation—positively impacting the world around us. Learn how we’re fulfilling this promise with our new DxH Concentrated ECO Diluent.
Read blogCustomizable configurations that give you added flexibility for greater control over your workflow
Built-in workflow automation
- Accommodate increasing sample-volume requirements with scalable, built-in automation solutions
- Prevent delays with a bi-directional sample transport system to distribute samples automatically between analyzers
- Add critical STAT samples or body fluids without the need to interrupt routine sample testing
- Prepare and stain slides automatically, without the need for manual intervention based on user-defined decision rules
Integrated for a seamless connection with increased data and quality control management
Maximize workflow efficiency
- Connect up to three DxH 900 hematology analyzers with a DxH Slidemaker Stainer II (SMS II) to form scalable and customized workflow solutions, compatible with DxA 5000 and DxA Fit 5000 lab automation and REMISOL Advance middleware
- Increase data management with database consolidation for order entry, results review (up to 90,000 results) and quality control management (30 control files, each with 150 runs per instrument)
- Load samples at a single instrument input buffer or at multiple instrument input buffers regardless of instrument position
- Manage pre- and post-analytical processes efficiently through our automation and clinical information systems offerings
DxH 900 Workcell Specification
Workcell | Configuration Detail | Maximum Throughput | Width | Depth | Height | Weight** |
DxH SMS II | 1 DxH SMS | 140 Smears/Hour | 94 cm (37 in) | 78.74 cm (31 in) | SMS; 204.5 cm (80.5 in) | 353.84 kg (780 lbs) |
DxH 900 | 1 DxH 900 | 100 Samples/Hour | 75.57 cm (29.75 in) | 82.80 cm (32.6 in) including the removable back panel 79.25 cm (31.2 in) excluding the removable back panel | DxH 900 174 cm (68.5 in) 194 cm (76.4 in) with cover lifted | 254 kg (560 lbs) |
DxH 900-S | 1 DxH 900 with SMS | 100 Samples/Hour | 170.53 cm (67.13 in) | 82.80 cm (32.6 in) including the removable back panel 79.25 cm (31.2 in) excluding the removable back panel | DxH 900 174 cm (68.5 in) 194 cm (76.4 in) with cover lifted | 608 kg (1340 lbs) |
DxH 900-2 | 2 DxH 900 | 200 Samples/Hour | 152.1 cm (59.88 in) | 82.80 cm (32.6 in) including the removable back panel 79.25 cm (31.2 in) excluding the removable back panel | DxH 900 174 cm (68.5 in) 194 cm (76.4 in) with cover lifted | 508 kg (1120 lbs) excluding reagents 680 kg (1500 lbs) including reagents |
DxH 900-3 | 3 DxH 900 | 300 Samples/Hour | 228.63 cm (90.01 in) | 82.80 cm (32.6 in) including the removable back panel 79.25 cm (31.2 in) excluding the removable back panel | DxH 900 174 cm (68.5 in) 194 cm (76.4 in) with cover lifted | 762 kg (1680 lbs) |
DxH 900-3S | 3 DxH 900 with SMS | 300 Samples/Hour | 323.59 cm (127.39 in) | 82.80 cm (32.6 in) including the removable back panel 79.25 cm (31.2 in) excluding the removable back panel | DxH 900 174 cm (68.5 in) 194 cm (76.4 in) with cover lifted | 1116 kg (2460 lbs) |
Additional clearance; 3.8 cm (1.5 in) behind instrument for sufficient cooling, 15.2 cm (6.0 in) per side.
Whole Blood | Reportable Range | Precision |
WBC x103 cells/μL | 0.050–400.000 | <3.0% -5% CV |
RBC x106 cells/μL | 0.005–8.500 | <1.5% CV |
HGB g/dL | 0.10–25.50 | <1.5% CV |
MCV fL | 50.00–150.00 | <1.0% CV |
PLT x103 cells/μL | 3.0–3000.00 | <3.5% CV |
MPV fL | 5.00–25.00 | <2.5% CV @PLT >100x103 cells/μL |
Body Fluid | Reportable Range | Precision |
TNC cells/mm3 | 20–89,000 | <10.0% CV |
RBC cells/mm3 | 1,000–6,200,000 | <15.0% CV |
Sample Aspiration |
Whole Blood and Body Fluid; 165 μL aspiration volume; 0.5 ml dead volume, Pre-dilute with X5 dilution mode; 50 μL whole blood into 200 μL of Diluent, SMS; 90 μL for up to 4 smears |
|
Methodology |
Enhanced Coulter Digital Impedance, 360 VCS with DataFusion | |
Available Test Menu |
CBC: WBC, RBC, HGB, HCT, MCV, MCH, MCHC, RDW, RDW-SD, PLT, MPV Differential: NE, LY, MO, EO, BA, MDW, NRBC, NE#, LY#, MO#, EO#, BA#, NRBC# Monocyte Distribution Width (MDW) (when enabled) Retic: RET, RET#, MRV, IRF Body fluids (CSF, Serous and Synovial): TNC, RBC, @BFM%, @BFP% |
|
Reagents (CBC/Diff/Retic)* and Controls |
Coulter DxH Diluent................628017 10 L Coulter DxH Cell Lyse............628019 5 L Coulter DxH Diff Pack............628020 EA Coulter DxH Retic Pack.........628021 EA |
6C Plus Cell Control 12x3.5 mL...........................PN C07297 6C Cell Control 9x3.5 mL......................................PN A59925 6C Cell Control 12x3.5 mL.....................................PN 628027 Latron Control 8x4 mL, CP-X..............................PN 628024 S-CAL Calibrator 1x3.3 mL....................................PN 628026 Reticulocyte Controls Retic-X (12x3.5 mL)...PN 628028 Body Fluid Control 12x3.5 mL.............................PN 628030 Linearity Product Lin-X..........................................PN 628029 |
Cleaner |
Coulter DxH Cleaner 628023 10 L—Preloaded for autonomous Daily Cleaning | |
Power Consumption |
Dual indentical power computers in a workcell. DxH 900 SPM; 520 W (1775 BTU/Hour), Monitor: 35W (120 BTU/Hour), DxH Server Computer: 160 W (546 BTU/Hour), DxH Slidemaker Stainer II SPM, 550 W (1877 BTU/Hour) | |
Data Management |
Up to 100,000 patient results with histograms, scatterplots and demographics | |
Quality Assurance |
QC with Levy-Jennings graph; XB/XM for moving averages, daily check, intelligent quality monitoring, customizable calibration and QC reminders and alerts, auto export of QC | |
Sample Transport |
Capacity: 20 five-tube cassettes per module (up to maximum of 400 samples with a DxH 900-3S). Barcodes: digital barcode with 2D barcode capability, Sample ID: up to 22 characters | |
Remote Monitoring |
PROService remote management system: maximum uptime with walk-away troubleshooting and preemptive alerts of instrument issues with RAP box | |
Power Supply Specifications |
A three-wire AC outlet, single phase power supplying 90-264 Vac at 48 to 63 Hz | |
Acoustic Noise Level |
60 dBa | |
Radio Frequency and Interference Immunity |
Meets by the product level standards EN 61326-1 (Electrical Equipment for Measurement, Control, and Laboratory Use - EMC Requirements), and EN 61326-2-6 |
*Cyanide free reagents
**Excluding reagents
DxH Concentrated Eco Diluent Specifications
RPI-ECO21 Instrument
Instrument size |
L 30.5 in (775 mm) x W 24.4 in (620 mm) x H 29.5 in (750 mm) |
Empty weight |
236 lbs. (107 Kg) including Millipore WPU AFS-24 |
Dilution method |
Electrical Conductivity and Temperature measurement (EC-T) |
Conductivity production range |
Upon request (indication 10 -20 mS/cm @25°C) |
Production capacity |
~20 L/hr. peak (for 3 hours) <17 L/hr. continuous (excluding lot-change and service) |
Number of DxH concentrated ECO Diluent |
2 x 10L, hot swappable for continuous 360L of diluted diluent |
Display specifications |
154 x 90 mm (7 in), 1024 x 600 resolution |
Storage medium |
Onboard memory & data export storage (USB) |
Stored data |
Batch production and reagent traceability information |
Data on Cubitainer NFC tag |
Reagent type, dilution target, origin, production date, lot number, ID, shelf life, remaining volume |
Eco-friendly DxH ECO Reagents to be used (cyanide-free and low formaldehyde ≤2 ppm)
Cubitainer positions and orientation |
2, upright for use in the diluter |
Cubitainer volume |
10L |
Concentration ratio |
18x |
Storage temperature |
Displayed in GUI and monitored (not controlled) |
Intra lot cubitainer switching |
Uninterrupted production |
Electrical requirements
Mains voltage |
115 or 230V (± 10%), 50-60 Hz (± 3%) |
Fuse EU |
2x 3.15A T (Slow blow) |
Fuse USA |
2x 6A T (Slow blow) |
Power consumption |
500 VA |
Built in Water Production Unit
Water Purification Unit (WPU) |
Merck Millipore AFS-24 |
Feed water temperature |
10 - 30°C |
Input water connection |
1x John Guest PM Acetal fitting 8 mm |
Produced water quality |
Clinical laboratory reagent water, conductivity ≥ 1MΩ/cm |
Input Water Parameters
Pressure |
1 to 6 bars |
Flow rate |
> 5 L/min at 2 bars |
Type |
Potable tap water |
Temperature |
10 – 30°C |
Conductivity |
100 – 2000 μS/cm @ 25°C |
pH |
4-10 |
Langelier Saturation Index (LSI) |
< 0.3 |
Free total chlorine |
< 3 ppm |
Concentrated Diluent Pack Control Process
Control method |
QC cycle using RPI-Check |
Frequency |
≥1x per 24 hr. in manual start and time scheduled |
With multiple available configurations and connectivity, the DxH 900 Connected Workcell has flexibility to meet your laboratory needs.
Workcell | Configuration Detail | Maximum Throughput |
DxH SlidemakerStainer II (SMS II) | 1 DxH SMS | 140 Smears/Hour |
DxH 900 | 1 DxH 900 | 100 Samples/Hour |
DxH 900-S | 1 DxH 900 with SMS | 100 Samples/Hour |
DxH 900-2 | 2 DxH 900 | 200 Samples/Hour |
DxH 900-2S | 2 DxH 900 with SMS | 200 Samples/Hour |
DxH 900-3 | 3 DxH 900 | 300 Samples/Hour |
DxH 900-3S | 3 DxH 900 with SMS | 300 Samples/Hour |
Multi-disciplinary Laboratory Solutions including Automation and Clinical Informatics to elevate patient care and drive laboratory efficiency.
DxA 5000 Fit | Designed to fit into small and mid-volume labs, the DxA 5000 Fit is a comprehensive workflow automation system that helps reduce up to 80% of manual steps through each step of the analytical process. The solution features Intelligent routing for rapid and consistent turnaround time and has a flexible design to meet tight space and infrastructure constraints. Up to 325 samples/hour with centrifuge connected or 375 samples/hour without centrifuge connected |
Click here |
DxA 5000 | The DxA 5000 helps laboratories meet the challenges of today’s healthcare environment with a new level of comprehensive pre-analytical sample quality detection of 9 parameters within 3 seconds. The automation system features dynamic software with Intelligent Routing that brings automated patient-centric workflow to the laboratory. Up to 1,200 samples per hour. |
Click here |
Power Express | Power Express provides the ultimate in connectivity – allowing you to connect all core disciplines into a single line – for faster turnaround time and quality results. Up to 1,450 samples per hour throughput with unspun tubes and bulk loader. |
Click here |
DxONE Inventory Manager | An automated, end-to-end software application that increases operational efficiency by automatically recording†, tracking and optimizing your laboratory’s consumables. |
Click here |
DxONE Workflow Manager | Amplify productivity and future-proof your lab by incorporating cloud-based middleware solution. Offering lower cost of ownership, scalability, autoverification, and ease of setup and use. |
Click here |
DxONE Command Central | Efficiently manage laboratory performance and productivity by establishing a centralized point of control connecting up to 18 instruments or automation systems across the network. |
Click here |
DxONE Insights | Identify patterns and reduce inefficiencies with this cloud-based software solution that provides actionable insights and lab data analytics to streamline operations. |
Click here |
REMISOL Advance | Increase lab productivity with continuous operation, powerful throughput and scalable capacity. With up to four modules, this chemistry analyzer can deliver up to 9,800 tests per hour. |
Click here |
PROService | A no added costs remote service tool. Maximizes instrument uptime and resolves issues with advance remote service access, enabling shortened service times |
Click here |
DxI 9000 | The DxI 9000 Access Immunoassay Analyzer sets a new standard for today’s busy labs. With meaningful innovations that amplify your impact, liberate you from the laborious, and power your performance across your health system, we’re taking diagnostics to the next level. |
Click here |
We offer product training courses and guides to give you the skills and knowledge you need to operate your clinical laboratory instruments.
See all product training courses and guides ›
DxH 900 Hematology Analyzer
Delivers the right results at the right time through VCS proprietary technology while streamlining processes that maximize laboratory staff time with fewer slide reviews and high system reliability for maximum uptime.

DxH Concentrated ECO Diluent
Reducing routine tasks and consolidating limited lab space are essential for today’s high-volume hematology labs. Optimize inventory management and reduce the risk of overexertion and physical stress with Eco Diluent, an 18x concentrated, eco-friendly solution that is 35% lighter than the competitor product.

Scopio Labs Digital Morphology Solution
The Scopio X100 and X100HT are transforming digital cell morphology analysis with Full-Field Peripheral Blood Smear™ Application and AI-based Decision Support System.
Educational Resources